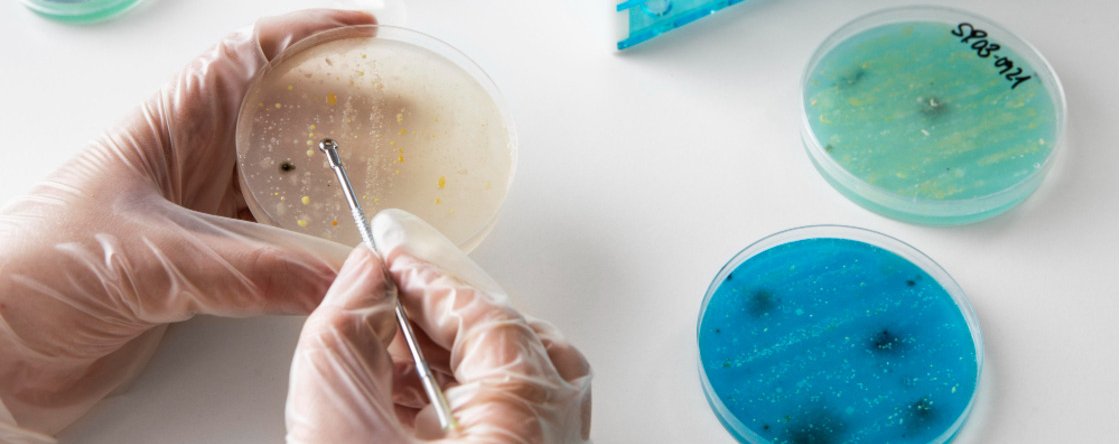
Come proteggersi dalla Candida auris?

Come proteggersi dalla Candida auris?
Cos’è la Candida auris
La candida auris è un lievito patogeno considerato una delle minacce più rilevanti per la sanità pubblica. Si tratta di un microrganismo appartenente al gruppo dei funghi della pelle, capace di colonizzare l’organismo umano e, in condizioni favorevoli, provocare infezioni gravi.
A differenza di altre specie di Candida più comuni, questo fungo ha sviluppato una spiccata resistenza ai farmaci antifungini e una notevole capacità di sopravvivere in diversi ambienti. Proprio per tali caratteristiche è spesso definito fungo killer, soprattutto quando colpisce persone fragili o con difese immunitarie compromesse.
Candida auris: sintomi
Uno degli aspetti più insidiosi della candida auris è la possibilità di essere già presente sulla pelle senza causare disturbi evidenti, infatti, molti soggetti risultano colonizzati, in particolare a livello cutaneo, senza manifestare segni clinici. La pelle rappresenta infatti il principale nascondiglio del microrganismo, soprattutto in zone come ascelle, inguine e pieghe cutanee.
Quando compaiono, i sintomi della candida auris variano in base alla sede dell’infezione e allo stato di salute della persona:
- Nelle forme invasive, il fungo può entrare nel circolo sanguigno causando candidemia, una condizione potenzialmente letale. In questi casi, i sintomi includono febbre persistente e brividi che non rispondono alle terapie antibiotiche, stanchezza intensa e peggioramento improvviso delle condizioni generali.
- In presenza di ferite, la candida auris può provocare infezioni locali con arrossamento, gonfiore, dolore e secrezioni purulente, accompagnate talvolta da febbre. Sono state descritte anche infezioni dell’orecchio, con dolore, secrezioni e riduzione dell’udito.
- Nei casi più gravi, quando il fungo si insinua in diversi fluidi corporei, si può arrivare a quadri clinici complessi come sepsi, infezioni cardiache, ossee o del sistema nervoso centrale.
Come proteggersi dalla candida auris
La protezione dalla candida auris si basa soprattutto sulla prevenzione, poiché attualmente non esistono strategie efficaci per eliminarla in modo definitivo nei soggetti asintomatici. Le misure di contenimento sono particolarmente importanti negli ambienti sanitari, dove il fungo trova condizioni ideali per diffondersi.
Prevenzione nelle strutture sanitarie
Una delle principali modalità di trasmissione avviene per contatto, sia esso diretto o indiretto. La candida auris è in grado di sopravvivere a lungo su superfici e oggetti, come letti ospedalieri, dispositivi medici, maniglie, telefoni e attrezzature sanitarie. Per questo motivo, l’igiene delle mani rappresenta la prima e più efficace forma di protezione: il lavaggio accurato con acqua e sapone o l’uso di soluzioni idroalcoliche riduce in modo significativo il rischio di diffusione.
Negli ospedali e nelle strutture assistenziali, la protezione passa anche attraverso l’uso corretto dei dispositivi di barriera, come guanti e camici monouso, soprattutto quando si entra in contatto con persone infette. L’isolamento dei pazienti positivi, quando possibile, contribuisce a limitare la trasmissione ad altri degenti, in particolare a quelli più vulnerabili.
Dato che non tutti i disinfettanti sono efficaci contro questo microrganismo, che può formare biofilm protettivi e resistere ai prodotti comunemente utilizzati contro altri funghi, la sanificazione accurata delle superfici con disinfettanti specifici o soluzioni a base di cloro è una misura essenziale per contenerne la diffusione.
Come proteggersi a casa
Al di fuori delle strutture sanitarie, è consigliabile evitare l’uso improprio di antibiotici e antifungini, poiché l’abuso di questi farmaci favorisce la selezione di microrganismi resistenti. Una buona igiene personale, soprattutto dopo visite o ricoveri ospedalieri, rappresenta una misura di buon senso per ridurre il rischio di trasmissione.
Nei soggetti dimessi da reparti ospedalieri o case di cura, l’attenzione all’igiene della pelle, alla gestione della biancheria e alla pulizia degli ambienti domestici aiuta a contenere la persistenza del fungo. Anche i familiari e i visitatori dovrebbero adottare comportamenti corretti, come il lavaggio frequente delle mani prima e dopo il contatto con la persona colonizzata.
Quando consultare un medico
Il consulto medico diventa fondamentale in presenza di sintomi sospetti, soprattutto nei soggetti a rischio: persone anziane, pazienti con malattie croniche, diabetici, individui immunodepressi o portatori di dispositivi invasivi dovrebbero prestare particolare attenzione a segnali come febbre persistente, brividi inspiegabili, peggioramento improvviso dello stato di salute o infezioni che non rispondono alle terapie abituali.
È opportuno rivolgersi a un medico anche in caso di infezioni cutanee o di ferite che mostrano segni di infiammazione persistente, dolore crescente o secrezioni anomale, specialmente dopo un ricovero ospedaliero.
La diagnosi precoce consente di avviare tempestivamente le misure di isolamento e il trattamento più appropriato, riducendo il rischio di complicanze e di diffusione ad altri pazienti. Anche in assenza di sintomi della candida evidenti, la segnalazione di una recente degenza in strutture sanitarie o di un contatto con casi noti può aiutare il personale medico a valutare l’opportunità di effettuare uno screening mirato.
Ciò che ci sentiamo di sottolineare è che, in un contesto in cui la candida auris continua a diffondersi a livello globale, la collaborazione tra cittadini e operatori sanitari rappresenta uno strumento essenziale per contenere un microrganismo che, per resistenza e capacità di adattamento, rimane una delle sfide più complesse della medicina moderna.
Se vuoi saperne di più su come proteggersi dalla candida auris, contattaci. I nostri esperti saranno felici di rispondere alle tue domande.

.png)








